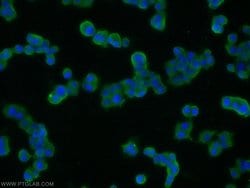
SNAP25 Rabbit anti-Human, Mouse, Rat, Polyclonal, Proteintech 20 &mu;L;

missing translation for 'onlineSavingsMsg'
Learn More
Learn More
SNAP25 Rabbit anti-Human, Mouse, Rat, Polyclonal, Proteintech
Rabbit Polyclonal Antibody
Brand: Proteintech 14903-1-AP-20UL
This item is not returnable.
View return policy
Description
SNAP25 is a t-SNARE involved in the molecular regulation of neurotransmitter release. It may play a role in the synaptic function of specific neuronal systems. SNAP25 associates with proteins involved in vesicle docking and membrane fusion. It also regulates plasma membrane recycling through its interaction with CENPF. Mutations in the gene can results in myasthenic syndrome.Specifications
| SNAP25 | |
| Polyclonal | |
| Unconjugated | |
| SNAP25 | |
| RIC 4, RIC4, SEC9, SNAP, SNAP 25, SNAP25, SUP, Super protein | |
| Rabbit | |
| Antigen Affinity Chromatography | |
| RUO | |
| 20614, 25012, 6616 | |
| -20°C | |
| Liquid |
| Immunoprecipitation, Western Blot, Immunofluorescence, Immunocytochemistry | |
| 0.48 mg/mL | |
| PBS with 50% glycerol and 0.02% sodium azide; pH 7.3 | |
| P60879, P60880, P60881 | |
| SNAP25 | |
| SNAP25 Fusion Protein Ag6695 | |
| 20 μL | |
| Primary | |
| Mouse, Rat, Human | |
| Antibody | |
| IgG |
Product Content Correction
Your input is important to us. Please complete this form to provide feedback related to the content on this product.
Product Title
Spot an opportunity for improvement?Share a Content Correction